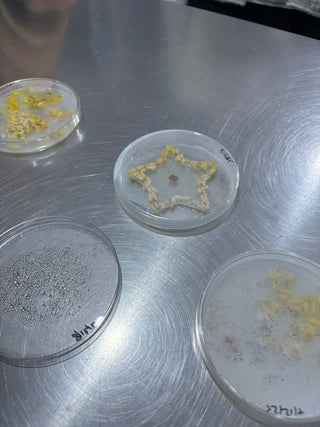
CLEAPSS Practical Science Training Session

Is Darwin Biological's bacteria safe for use in schools?
All our bacteria cultures are safe for use in schools. All cultures are checked for purity before dispatch and are considered non-pathogenic. However, due to the possibility of contamination and mutation all bacteria should be treated as potentially dangerous. Your employer is responsible for ensuring health & safety in the workplace - when considering practical activities using bacteria you are required to follow all guidance provided by your employer. We recommend using aseptic techniques.
Safety Information
All bacteria are sold at customer's own risk and appropriate risk assessments must be completed under COSHH before proceeding, considering both the ACDP and COSHH regulations, but also considering the risk to young people as a susceptible group. No responsibility will be taken for any accidents resulting from misuse.
- ACDP Hazard Group 1
- Cultures are non-returnable
- For UK educational purposes only
- Not for human consumption.
Click here to view the Safety Data Sheet
What is good aseptic technique?
- Wear a clean lab coat and wash your hands thoroughly before and after
- Never eat in the laboratory or store cultures where food may be stored
- Surfaces should be disinfected with an anti-bacterial cleaner before and after use
- Complete all operations as quickly as possible but without rushing
- All items in contact with bacteria should be sterilised/autoclaved before & after use
- All cultures should be clearly labelled with strain and date
How long can you keep bacteria cultures?
Our bacteria cultures are dispatched when strongly growing and should used soon after receipt. The longer a culture is kept the weaker it will be, so ideally it should be used or transferred onto fresh medium within 2 weeks. We advise storing in the fridge (around 4°C), as this slows down the growth meaning some of the stronger strains of bacteria can last longer, but again, the longer they are kept the weaker they will be. We can only guarantee unopened bacteria for 2 months from the date of manufacture (DOM).
The date printed on the glass bottle indicates the expiry date of the agar itself, not the bacteria. After this date the agar is no longer guaranteed to be sterile – however, once we add bacteria the slope is not sterile anyway so it’s irrelevant!
How should you store bacteria?
We advise storing in the fridge (around 4°C) as this slows down the growth. Bring up to room temperature before using.
How do you subculture bacteria?
Use a sterile inoculating loop to scrape a small amount of the bacteria off the surface of the agar slope, then gently transfer this onto the new sterile medium - either a nutrient agar slope, nutrient agar petri dish or bottle containing nutrient broth. It is always advisable to also transfer to at least one agar slope, which can then be stored in the fridge as a back up culture should your working cultures become contaminated.
Once inoculated, incubate at 25°C for 24-48 hours.
Where does Darwin Biological's bacteria come from?
All Darwin’s bacteria cultures are derived from strains held by the British National Culture Collection (NCTC). Founded in 1920, the NCTC is the longest-established collection of its type anywhere in the world and is operated by UKHSA (formerly Public Health England). The bacteria that the collection houses is used globally, in total they have over 5000 strains including samples deposited by Sir Alexander Fleming himself!
Here at Darwin we are proud to support such a British institution by purchasing all starter cultures from the NCTC. These cultures are then sub-cultured before being applied to slopes; by sub-culturing we are able to supply quality bacteria at affordable prices. Our bacteria is a maximum of 4 passages away from the Culture Collection’s original. If you require fewer passages, we recommend you purchase directly from the NCTC.
Where can you get further information?
For further resources see the Microbiology Society (e.g. Basic Practical Microbiology manual) and CLEAPSS websites.